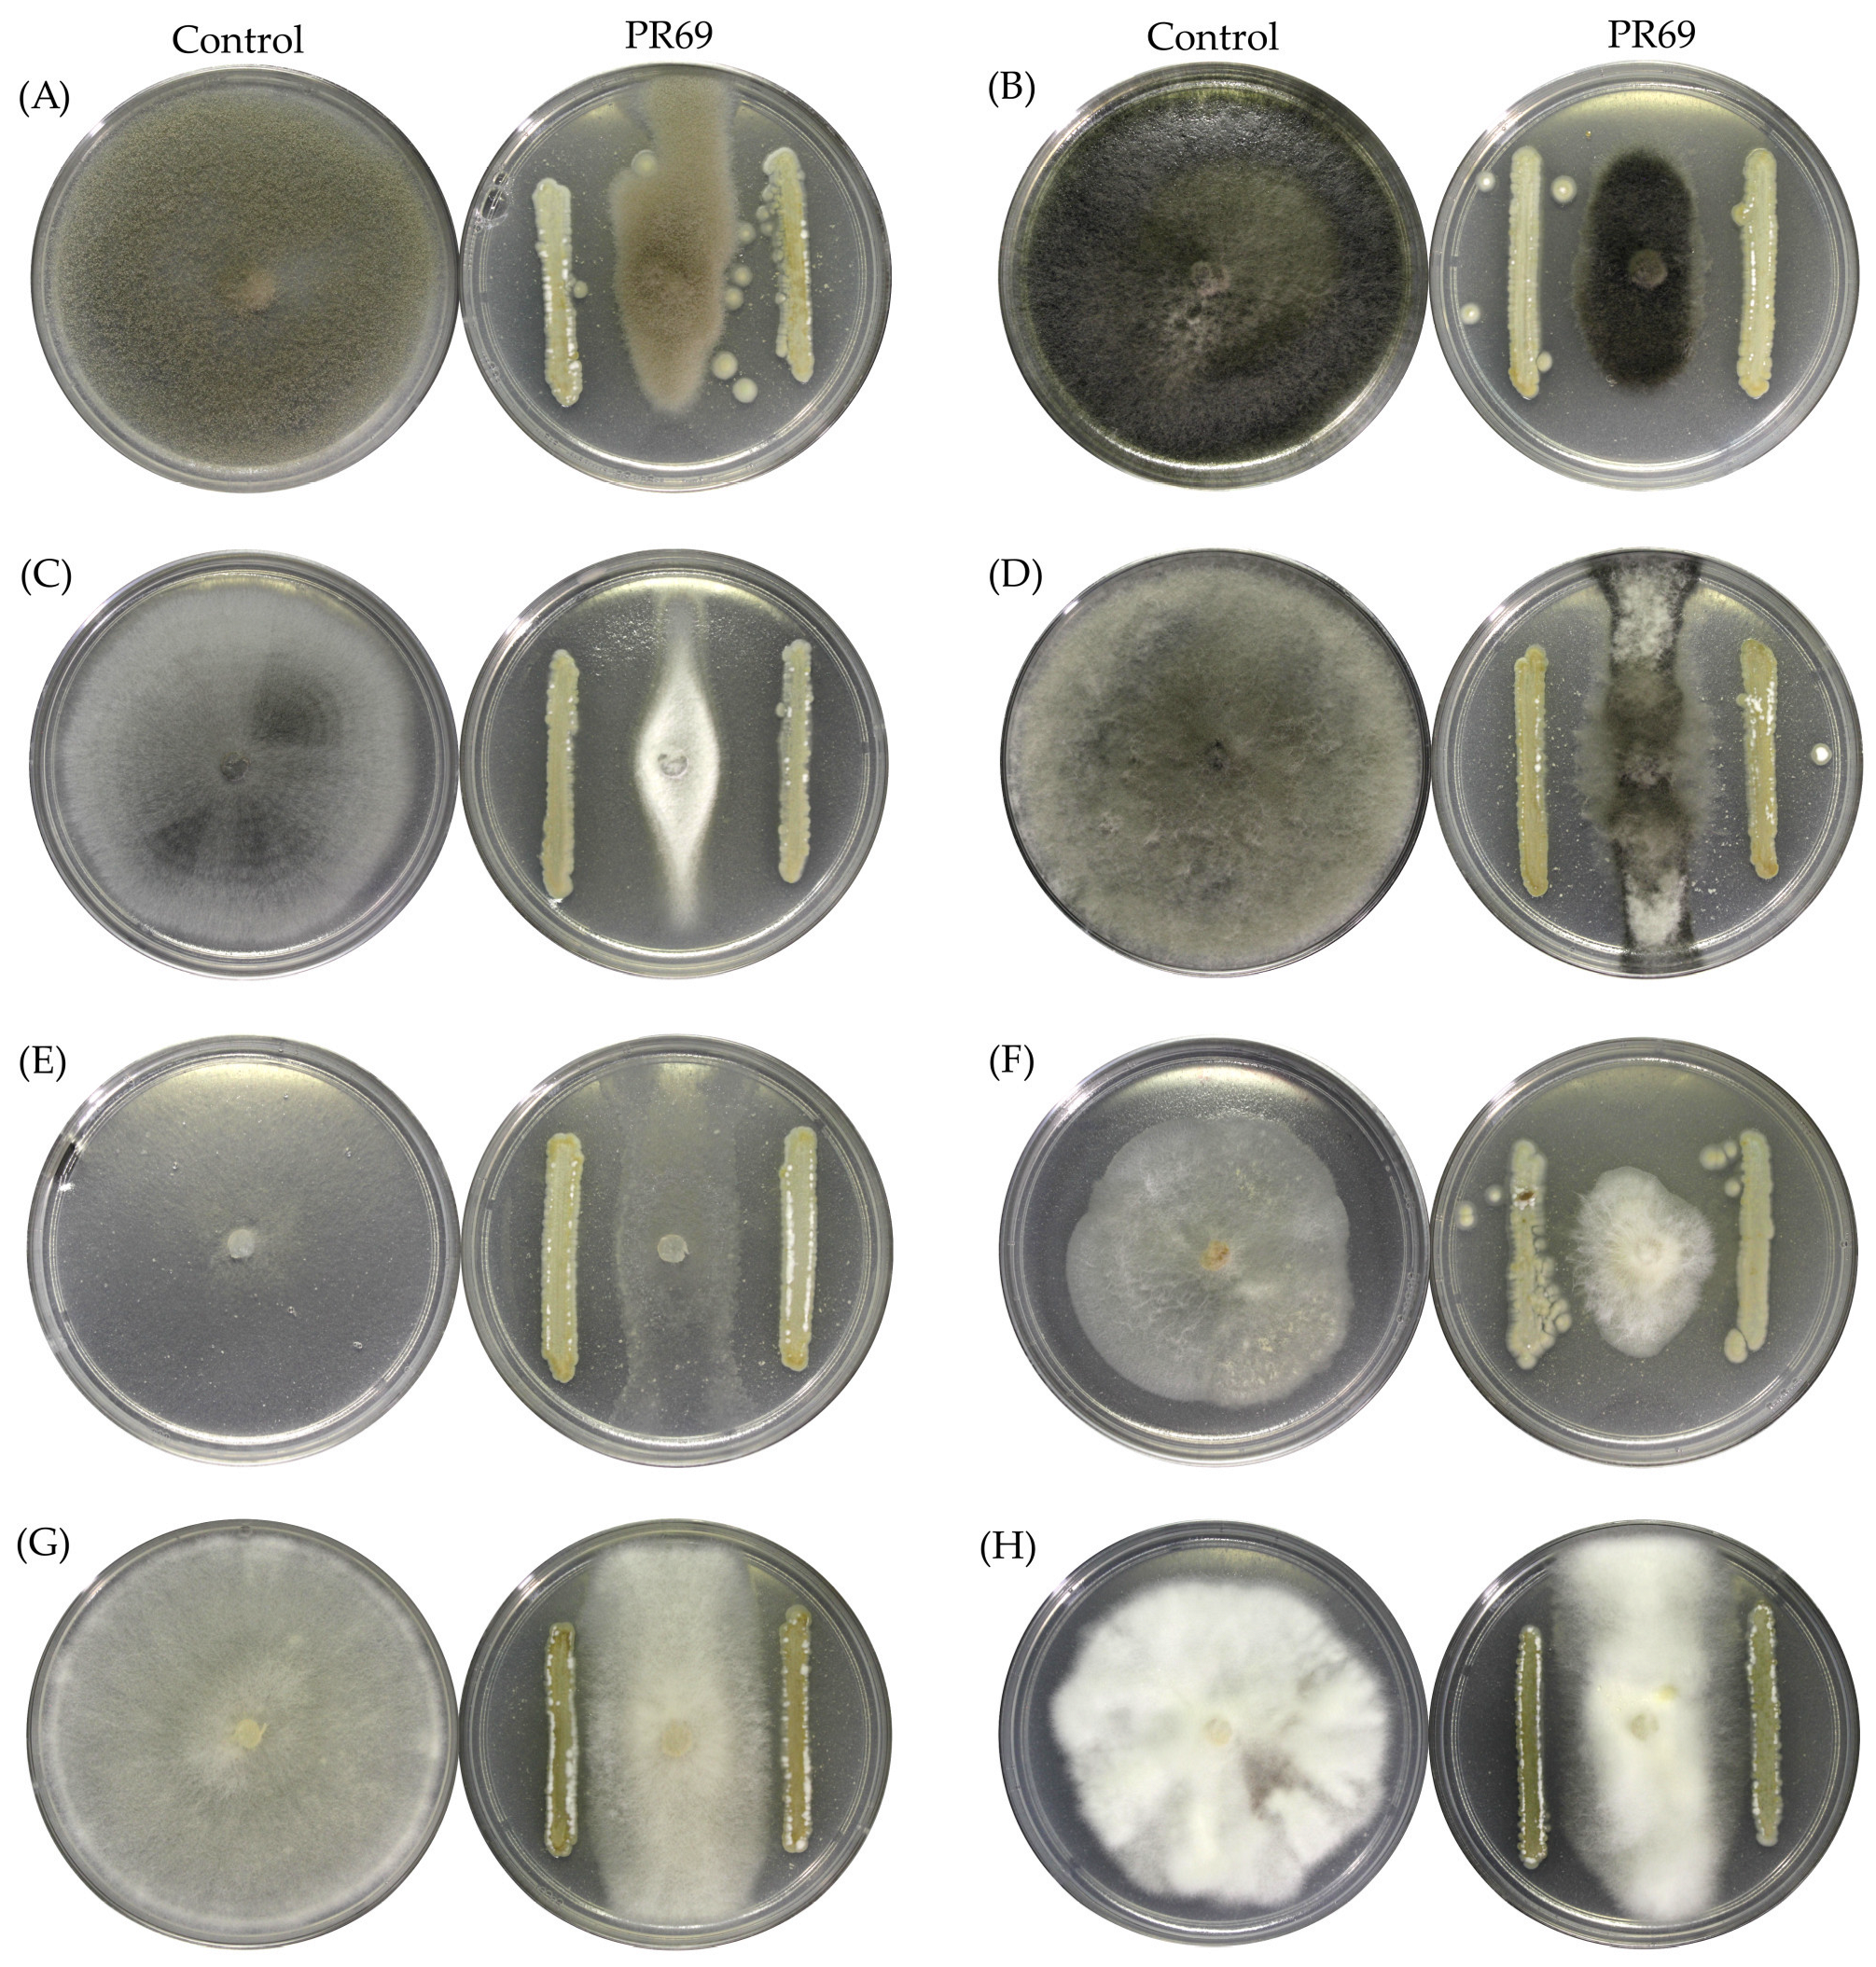
Horticulturae 10 01365 g002

Biological Control of Streptomyces sp. PR69 Against Phytophthora capsici and Its Growth-Promoting Effects on Plants
Abstract
1. Introduction
2. Materials and Methods
2.1. Bacterial Strain and Fungal Plant Pathogens and Seeds
2.2. Screening of Actinobacteria with Antagonistic Properties
2.3. Antifungal Activity In Vitro
2.4. VOC-Mediated Antifungal Activity
2.5. Morphological and Culture Characterization
2.6. Genome Sequencing, Assembly, and Bioinformatics Analysis
2.7. Production of Extracellular Enzymes and Biochemical Characterization
2.8. VOC-Mediated Plant Growth Promotion on A. thaliana
2.9. Inoculation of Bell Pepper Plants with Streptomyces sp. PR69 and Phytophthora capsici
2.10. Statistical Analysis
3. Results
3.1. Antifungal Activity In Vitro
3.2. Morphological and Culture Characterization
3.3. Genome Sequencing, Assembly, and Bioinformatics Analysis
3.4. Production of Extracellular Enzymes and Biochemical Characterization
3.5. VOC-Mediated Plant Growth Promotion on A. thaliana
3.6. Inoculation of Bell Pepper Plants with Streptomyces sp. PR69 and Phytophthora Capsici
4. Discussion
5. Conclusions
Supplementary Materials
Author Contributions
Funding
Data Availability Statement
Acknowledgments
Conflicts of Interest
References
- Flores-Velazquez, J.; Mendoza-Perez, C.; Rubiños-Panta, J.E.; Ruelas-Islas, J.D. Quality and Yield of Bell Pepper Cultivated with Two and Three Stems in a Modern Agriculture System. Horticulturae 2022, 8, 1187. [Google Scholar] [CrossRef]
- Saltos, L.A.; Corozo-Quiñones, L.; Pacheco-Coello, R.; Santos-Ordóñez, E.; Monteros-Altamirano, Á.; Garcés-Fiallos, F.R. Tissue specific colonization of Phytophthora capsici in Capsicum spp.: Molecular insights over plant-pathogen interaction. Phytoparasitica 2021, 49, 113–122. [Google Scholar] [CrossRef]
- Wang, W.; Liu, X.; Han, T.; Li, K.; Qu, Y.; Gao, Z. Differential Potential of Phytophthora capsici Resistance Mechanisms to the Fungicide Metalaxyl in Peppers. Microorganisms 2020, 8, 278. [Google Scholar] [CrossRef] [PubMed]
- Siegenthaler, T.B.; Hansen, Z.R. Sensitivity of Phytophthora capsici from Tennessee to Mefenoxam, Fluopicolide, Oxathiapiprolin, Dimethomorph, Mandipropamid, and Cyazofamid. Plant Dis. 2021, 105, 3000–3007. [Google Scholar] [CrossRef]
- Hu, Z. What Socio-Economic and Political Factors Lead to Global Pesticide Dependence? A Critical Review from a Social Science Perspective. Int. J. Environ. Res. Public Health 2020, 17, 8119. [Google Scholar] [CrossRef]
- Bonaterra, A.; Badosa, E.; Daranas, N.; Francés, J.; Roselló, G.; Montesinos, E. Bacteria as Biological Control Agents of Plant Diseases. Microorganisms 2022, 10, 1759. [Google Scholar] [CrossRef] [PubMed]
- Souza, V.; Moreno-Letelier, A.; Travisano, M.; Alcaraz, L.D.; Olmedo, G.; Eguiarte, L.E. The lost world of cuatro ciénegas basin, a relictual bacterial niche in a desert oasis. eLife 2018, 7, e38278. [Google Scholar] [CrossRef] [PubMed]
- Peralta-García, C.; Sánchez-Coronado, M.E.; Orozco-Segovia, A.; Orozco-Segovia, S.; Pisanty-Baruch, I. Germination of four riparian species in a disturbed semi-arid ecosystem. S. Afr. J. Bot. 2016, 106, 110–118. [Google Scholar] [CrossRef]
- García-Ulloa, M.; Souza, V.; Esquivel-Hernández, D.A.; Sánchez-Pérez, J.; Espinosa-Asuar, L.; Viladomat, M.; Marroquín-Rodríguez, M.; Navarro-Miranda, M.; Ruiz-Padilla, J.; Monroy-Guzmán, C.; et al. Recent Differentiation of Aquatic Bacterial Communities in a Hydrological System in the Cuatro Ciénegas Basin, After a Natural Perturbation. Front. Microbiol. 2022, 13, 825167. [Google Scholar] [CrossRef]
- Arocha-Garza, H.F.; Canales-Del Castillo, R.; Eguiarte, L.E.; Souza, V.; De la Torre-Zavala, S. High diversity and suggested endemicity of culturable Actinobacteria in an extremely oligotrophic desert oasis. PeerJ 2017, 5, e3247. [Google Scholar] [CrossRef]
- Liotti, R.G.; da Silva Figueiredo, M.I.; Soares, M.A. Streptomyces griseocarneus R132 controls phytopathogens and promotes growth of pepper (Capsicum annuum). Biol. Control 2019, 138, 104065. [Google Scholar] [CrossRef]
- Cordovez, V.; Carrion, V.J.; Etalo, D.W.; Mumm, R.; Zhu, H.; van Wezel, G.P.; Raaijmakers, J.M. Diversity and functions of volatile organic compounds produced by Streptomyces from a disease-suppressive soil. Front. Microbiol. 2015, 6, 1–13. [Google Scholar] [CrossRef] [PubMed]
- Gurevich, A.; Saveliev, V.; Vyahhi, N.; Tesler, G. QUAST: Quality assessment tool for genome assemblies. Bioinformatics 2013, 29, 1072–1075. [Google Scholar] [CrossRef]
- Kim, J.; Na, S.-I.; Kim, D.; Chun, J. UBCG2: Up-to-date bacterial core genes and pipeline for phylogenomic analysis. J. Microbiol. 2021, 59, 609–615. [Google Scholar] [CrossRef] [PubMed]
- Yoon, S.-H.; Ha, S.-m.; Lim, J.; Kwon, S.; Chun, J. A large-scale evaluation of algorithms to calculate average nucleotide identity. Antonie Van Leeuwenhoek 2017, 110, 1281–1286. [Google Scholar] [CrossRef] [PubMed]
- Rodriguez-R, L.M.; Konstantinidis, K.T. The enveomics collection: A toolbox for specialized analyses of microbial genomes and metagenomes. PeerJ Prepr. 2016, 4, e1900v1901. [Google Scholar] [CrossRef]
- Meier-Kolthoff, J.P.; Carbasse, J.S.; Peinado-Olarte, R.L.; Göker, M. TYGS and LPSN: A database tandem for fast and reliable genome-based classification and nomenclature of prokaryotes. Nucleic Acids Res. 2022, 50, D801–D807. [Google Scholar] [CrossRef] [PubMed]
- Aziz, R.K.; Bartels, D.; Best, A.A.; DeJongh, M.; Disz, T.; Edwards, R.A.; Formsma, K.; Gerdes, S.; Glass, E.M.; Kubal, M.; et al. The RAST Server: Rapid Annotations using Subsystems Technology. BMC Genom. 2008, 9, 75. [Google Scholar] [CrossRef]
- Blin, K.; Shaw, S.; Augustijn, H.E.; Reitz, Z.L.; Biermann, F.; Alanjary, M.; Fetter, A.; Terlouw, B.R.; Metcalf, W.W.; Helfrich, E.J.N.; et al. antiSMASH 7.0: New and improved predictions for detection, regulation, chemical structures and visualisation. Nucleic Acids Res. 2023, 51, W46–W50. [Google Scholar] [CrossRef]
- Ortiz Lechuga, E.G.; Quintero Zapata, I.; Arévalo Niño, K. Detection of extracellular enzymatic activity in microorganisms isolated from waste vegetable oil contaminated soil using plate methodologies. Afr. J. Biotechnol. 2016, 15, 408–416. [Google Scholar] [CrossRef]
- Mun, B.G.; Lee, W.H.; Kang, S.M.; Lee, S.U.; Lee, S.M.; Lee, D.Y.; Shahid, M.; Yun, B.W.; Lee, I.J. Streptomyces sp. LH 4 promotes plant growth and resistance against Sclerotinia sclerotiorum in cucumber via modulation of enzymatic and defense pathways. Plant Soil 2020, 448, 87–103. [Google Scholar] [CrossRef]
- Joe, S.; Sarojini, S. An Efficient Method of Production of Colloidal Chitin for Enumeration of Chitinase Producing Bacteria. Mapana J. Sci. 2017, 16, 37–45. [Google Scholar] [CrossRef]
- Hu, Q.-P.; Xu, J.-G. A simple double-layered chrome azurol S agar (SD-CASA) plate assay to optimize the production of siderophores by a potential biocontrol agent Bacillus. Afr. J. Microbiol. Res. 2011, 5, 4321–4327. [Google Scholar] [CrossRef]
- Abbasi, S.; Safaie, N.; Sadeghi, A.; Shamsbakhsh, M. Streptomyces Strains Induce Resistance to Fusarium oxysporum f. Sp. Lycopersici Race 3 in Tomato through Different Molecular Mechanisms. Front. Microbiol. 2019, 10, 1505. [Google Scholar] [CrossRef]
- Zong, G.; Zhong, C.; Fu, J.; Zhao, Z.; Cao, G. Complete Genome Sequence of the High-Natamycin-Producing Strain Streptomyces gilvosporeus F607. Genome Announc. 2018, 6, e01402-17. [Google Scholar] [CrossRef] [PubMed]
- Zhu, Q.; Cheng, W.; Song, Y.; He, Q.; Ju, J.; Li, Q. Complete genome sequence of the deep South China Sea-derived Streptomyces niveus SCSIO 3406, the producer of cytotoxic and antibacterial marfuraquinocins. PLoS ONE 2021, 16, e0248404. [Google Scholar] [CrossRef] [PubMed]
- Zhu, P.; Xu, Y.; Fu, J.; Liao, Y. Streptomyces qinzhouensis sp. Nov., a mangrove soil actinobacterium. Int. J. Syst. Evol. Microbiol. 2020, 70, 1800–1804. [Google Scholar] [CrossRef]
- Zhou, S.; Yang, X.; Huang, D.; Huang, X. Streptomyces solisilvae sp. Nov., isolated from tropical forest soil. Int. J. Syst. Evol. Microbiol. 2017, 67, 3553–3558. [Google Scholar] [CrossRef]
- Zhou, S.; Xiao, K.; Huang, D.; Wu, W.; Xu, Y.; Xia, W.; Huang, X. Complete genome sequence of Streptomyces spongiicola HNM0071 T, a marine sponge-associated actinomycete producing staurosporine and echinomycin. Mar. Genom. 2019, 43, 61–64. [Google Scholar] [CrossRef]
- Zheng, S.; Zhu, Y.; Liu, K.; Li, J. Complete genome sequence analysis of a novel granaticin producer, Streptomyces sp. A1013Y. Res. Sq. Prepr. 2020. [Google Scholar] [CrossRef]
- Zhao, X.; Yang, T. Draft genome sequence of the marine sediment-derived actinomycete Streptomyces xinghaiensis NRRL B24674 T. J. Bacteriol. 2011, 193, 5543. [Google Scholar] [CrossRef] [PubMed]
- Zhao, J.; Tang, X.; Li, K.; Guo, Y.; Feng, M.; Gao, J. Streptomyces paludis sp. Nov., isolated from an alpine wetland soil. Int. J. Syst. Evol. Microbiol. 2020, 70, 773–778. [Google Scholar] [CrossRef]
- Zhang, J.; He, Z.; Xu, J.; Song, S.; Zhu, Q.; Wu, G.; Guan, Y.; Wu, X.; Yue, R.; Wang, Y.; et al. Semi-rational mutagenesis of an industrial Streptomyces fungicidicus strain for improved enduracidin productivity. Appl. Microbiol. Biotechnol. 2020, 104, 3459–3471. [Google Scholar] [CrossRef] [PubMed]
- Zhang, J.; Chen, J.; Hu, L.; Jia, R.; Ma, Q.; Tang, J.; Wang, Y. Antagonistic action of Streptomyces pratensis S10 on Fusarium graminearum and its complete genome sequence. Environ. Microbiol. 2021, 23, 1925–1940. [Google Scholar] [CrossRef] [PubMed]
- Zhang, H.Y.; Xie, Z.P.; Lou, T.T.; Wang, S.Y. Complete Genome Sequence of Streptomyces olivoreticuli ATCC 31159 Which can Produce Anticancer Bestatin and Show Diverse Secondary Metabolic Potentials. Curr. Microbiol. 2019, 76, 370–375. [Google Scholar] [CrossRef] [PubMed]
- Zhang, C.; Ding, W.; Qin, X.; Ju, J. Genome Sequencing of Streptomyces olivaceus SCSIO T05 and Activated Production of Lobophorin CR4 via Metabolic Engineering and Genome Mining. Mar. Drugs 2019, 17, 593. [Google Scholar] [CrossRef]
- Zhang, B.; Tang, S.; Yang, R.; Chen, X.; Zhang, D.; Zhang, W.; Li, S.; Chen, T.; Liu, G.; Dyson, P. Streptomyces dangxiongensis sp. Nov., isolated from soil of Qinghai-Tibet Plateau. Int. J. Syst. Evol. Microbiol. 2019, 69, 2729–2734. [Google Scholar] [CrossRef]
- Zhang, B.; Tang, S.; Chen, X.; Zhang, G.; Zhang, W.; Chen, T.; Liu, G.; Li, S.; Dos Santos, L.T.; Castro, H.C.; et al. Streptomyces qaidamensis sp. nov., isolated from sand in the Qaidam Basin, China. J. Antibiot. 2018, 71, 880–886. [Google Scholar] [CrossRef] [PubMed]
- Yu, L.; Zhou, W.; She, Y.; Ma, H.; Cai, Y.-S.; Jiang, M.; Deng, Z.; Price, N.P.J.; Chen, W. Efficient biosynthesis of nucleoside cytokinin angustmycin A containing an unusual sugar system. Nat. Commun. 2021, 12, 6633. [Google Scholar] [CrossRef] [PubMed]
- Yin, M.; Jiang, M.; Ren, Z.; Dong, Y.; Lu, T. The complete genome sequence of Streptomyces autolyticus CGMCC 0516, the producer of geldanamycin, autolytimycin, reblastatin and elaiophylin. J. Biotechnol. 2017, 252, 27–31. [Google Scholar] [CrossRef] [PubMed]
- Xu, Y.; Tan, G.; Ke, M.; Li, J.; Tang, Y.; Meng, S.; Niu, J.; Wang, Y.; Liu, R.; Wu, H.; et al. Enhanced lincomycin production by co-overexpression of metK1 and metK2 in Streptomyces lincolnensis. J. Ind. Microbiol. Biotechnol. 2018, 45, 345–355. [Google Scholar] [CrossRef] [PubMed]
- Wu, L.; Chen, G.; Feng, G. Complete genome sequence of Streptomyces griseochromogenes ATCC 14511T, a producer of nucleoside compounds and diverse secondary metabolites. J. Biotechnol. 2017, 249, 16–19. [Google Scholar] [CrossRef] [PubMed]
- Wu, H.; Qu, S.; Lu, C.; Zheng, H.; Zhou, X.; Bai, L.; Deng, Z. Genomic and transcriptomic insights into the thermo-regulated biosynthesis of validamycin in Streptomyces hygroscopicus 5008. BMC Genom. 2012, 13, 337. [Google Scholar] [CrossRef] [PubMed]
- Wu, H.; Liu, W.; Shi, L.; Si, K.; Liu, T.; Dong, D.; Zhang, T.; Zhao, J.; Liu, D.; Tian, Z.; et al. Comparative Genomic and Regulatory Analyses of Natamycin Production of Streptomyces lydicus A02. Sci. Rep. 2017, 7, 9114. [Google Scholar] [CrossRef] [PubMed]
- Wang, X.J.; Yan, Y.J.; Zhang, B.; An, J.; Wang, J.J.; Tian, J.; Jiang, L.; Chen, Y.H.; Huang, S.X.; Yin, M.; et al. Genome sequence of the milbemycin-producing bacterium Streptomyces bingchenggensis. J. Bacteriol. 2010, 192, 4526–4527. [Google Scholar] [CrossRef]
- Wang, X.; Ning, X.; Zhao, Q.; Kang, Q.; Bai, L. Improved PKS Gene Expression With Strong Endogenous Promoter Resulted in Geldanamycin Yield Increase. Biotechnol. J. 2017, 12, 1700321. [Google Scholar] [CrossRef]
- Wang, L.; Wang, S.; He, Q.; Yu, T.; Li, Q.; Hong, B. Draft Genome Sequence of Streptomyces globisporus C-1027, Which Produces an Antitumor Antibiotic Consisting of a Nine-Membered Enediyne with a Chromoprotein. J. Bacteriol. 2012, 194, 4144. [Google Scholar] [CrossRef] [PubMed][Green Version]
- Wang, C.; Wang, Y.; Ma, J.; Hou, Q.; Liu, K.; Ding, Y.; Du, B. Screening and Whole-Genome Sequencing of Two Streptomyces Species from the Rhizosphere Soil of Peony Reveal Their Characteristics as Plant Growth-Promoting Rhizobacteria. BioMed Res. Int. 2018, 2018, 1–11. [Google Scholar] [CrossRef]
- Vargas Hoyos, H.A.; Santos, S.N.; Padilla, G.; Melo, I.S. Genome Sequence of Streptomyces cavourensis 1AS2a, a Rhizobacterium Isolated from the Brazilian Cerrado Biome. Microbiol. Resour. Announc. 2019, 8, e00065-19. [Google Scholar] [CrossRef]
- Tian, J.; Yang, J.; Li, L.; Ruan, L.; Wei, W.; Zheng, G.; Zhao, W.; Chen, J.; Jiang, W.; Ge, M.; et al. The complete genome sequence of a high pristinamycin-producing strain Streptomyces pristinaespiralis HCCB10218. J. Biotechnol. 2015, 214, 45–46. [Google Scholar] [CrossRef]
- Thibessard, A.; Haas, D.; Gerbaud, C.; Aigle, B.; Lautru, S.; Pernodet, J.L.; Leblond, P. Complete genome sequence of Streptomyces ambofaciens ATCC 23877, the spiramycin producer. J. Biotechnol. 2015, 214, 117–118. [Google Scholar] [CrossRef]
- Tang, X.; Zhao, J.; Li, K.; Chen, Z.; Sun, Y.; Gao, J. Streptomyces cyaneochromogenes sp. nov., a blue pigment-producing actinomycete from manganese-contaminated soil. Int. J. Syst. Evol. Microbiol. 2019, 69, 2202–2207. [Google Scholar] [CrossRef] [PubMed]
- Sweeney, P.; Murphy, C.D.; Caffrey, P. Exploiting the genome sequence of Streptomyces nodosus for enhanced antibiotic production. Appl. Microbiol. Biotechnol. 2016, 100, 1285–1295. [Google Scholar] [CrossRef]
- Sun, J.; Zhao, G.; O’Connor, R.D.; Davison, J.R.; Bewley, C.A. Vertirhodins A-F, C-Linked Pyrrolidine-Iminosugar-Containing Pyranonaphthoquinones from Streptomyces sp. B15-008. Org. Lett. 2021, 23, 682–686. [Google Scholar] [CrossRef]
- Sinha, A.; Phillips-Salemka, S.; Niraula, T.A.; Short, K.A.; Niraula, N.P. The complete genomic sequence of Streptomyces spectabilis NRRL-2792 and identification of secondary metabolite biosynthetic gene clusters. J. Ind. Microbiol. Biotechnol. 2019, 46, 1217–1223. [Google Scholar] [CrossRef]
- Sichtig, H.; Minogue, T.; Yan, Y.; Stefan, C.; Hall, A.; Tallon, L.; Sadzewicz, L.; Nadendla, S.; Klimke, W.; Hatcher, E.; et al. FDA-ARGOS is a database with public quality-controlled reference genomes for diagnostic use and regulatory science. Nat. Commun. 2019, 10, 3313. [Google Scholar] [CrossRef] [PubMed]
- Shao, H.; Chen, M.; Fei, X.; Zhang, R.; Zhong, Y.; Ni, W.; Tao, X.; He, X.; Zhang, E.; Yong, B.; et al. Complete genome sequence and characterization of a polyethylene biodegradation strain, Streptomyces albogriseolus LBX-2. Microorganisms 2019, 7, 379. [Google Scholar] [CrossRef]
- Schneider, B.; Pfeiffer, F.; Dyall-Smith, M.; Kunte, H.-J. Genome Sequence of Micromonospora aurantiaca Strain G9, a Member of a Bacterial Consortium Capable of Polyethylene Degradation. Microbiol. Resour. Announc. 2022, 11, e01148-21. [Google Scholar] [CrossRef]
- Rückert, C.; Szczepanowski, R.; Albersmeier, A.; Goesmann, A.; Iftime, D.; Musiol, E.M.; Blin, K.; Wohlleben, W.; Pühler, A.; Kalinowski, J.; et al. Complete genome sequence of the kirromycin producer Streptomyces collinus Tü 365 consisting of a linear chromosome and two linear plasmids. J. Biotechnol. 2013, 168, 739–740. [Google Scholar] [CrossRef]
- Rückert, C.; Albersmeier, A.; Busche, T.; Jaenicke, S.; Winkler, A.; Friðjónsson, Ó.H.; Hreggviðsson, G.Ó.; Lambert, C.; Badcock, D.; Bernaerts, K.; et al. Complete genome sequence of Streptomyces lividans TK24. J. Biotechnol. 2015, 199, 21–22. [Google Scholar] [CrossRef]
- Risdian, C.; Landwehr, W.; Rohde, M.; Schumann, P.; Hahnke, R.L.; Spröer, C.; Bunk, B.; Kämpfer, P.; Schupp, P.J.; Wink, J. Streptomyces bathyalis sp. nov., an actinobacterium isolated from the sponge in a deep sea. Antonie Van Leeuwenhoek Int. J. Gen. Mol. Microbiol. 2021, 114, 425–435. [Google Scholar] [CrossRef] [PubMed]
- Ramesh, C.; Anwesh, M.; Vinithkumar, N.V.; Kirubagaran, R.; Dufossé, L. Complete genome analysis of undecylprodigiosin pigment biosynthesizing marine Streptomyces species displaying potential bioactive applications. Microorganisms 2021, 9, 2249. [Google Scholar] [CrossRef]
- Pethick, F.E.; MacFadyen, A.C.; Tang, Z.; Sangal, V.; Liu, T.T.; Chu, J.; Kosec, G.; Petkovic, H.; Guo, M.; Kirby, R.; et al. Draft genome sequence of the oxytetracycline-producing bacterium Streptomyces rimosus ATCC 10970. Genome Announc. 2013, 1, e00063-13. [Google Scholar] [CrossRef] [PubMed]
- Park, J.S.; Kim, D.E.; Hong, S.C.; Kim, S.Y.; Kwon, H.C.; Hyun, C.G.; Choi, J. Genome analysis of Streptomyces nojiriensis jcm 3382 and distribution of gene clusters for three antibiotics and an azasugar across the genus Streptomyces. Microorganisms 2021, 9, 1802. [Google Scholar] [CrossRef] [PubMed]
- Ortseifen, V.; Winkler, A.; Albersmeier, A.; Wendler, S.; Pühler, A.; Kalinowski, J.; Rückert, C. Complete genome sequence of the actinobacterium Streptomyces glaucescens GLA.O (DSM 40922) consisting of a linear chromosome and one linear plasmid. J. Biotechnol. 2015, 194, 81–83. [Google Scholar] [CrossRef] [PubMed]
- Omura, S.; Ikeda, H.; Ishikawa, J.; Hanamoto, A.; Takahashi, C.; Shinose, M.; Takahashi, Y.; Horikawa, H.; Nakazawa, H.; Osonoe, T.; et al. Genome sequence of an industrial microorganism Streptomyces avermitilis: Deducing the ability of producing secondary metabolites. Proc. Natl. Acad. Sci. USA 2001, 98, 12215–12220. [Google Scholar] [CrossRef] [PubMed]
- Ohnishi, Y.; Ishikawa, J.; Hara, H.; Suzuki, H.; Ikenoya, M.; Ikeda, H.; Yamashita, A.; Hattori, M.; Horinouchi, S. Genome sequence of the streptomycin-producing microorganism Streptomyces griseus IFO 13350. J. Bacteriol. 2008, 190, 4050–4060. [Google Scholar] [CrossRef]
- Nishizawa, T.; Miura, T.; Harada, C.; Guo, Y.; Narisawa, K.; Ohta, H.; Takahashi, H.; Shirai, M. Complete Genome Sequence of Streptomyces parvulus 2297, Integrating Site-Specifically with Actinophage R4. Genome Announc. 2016, 4. [Google Scholar] [CrossRef] [PubMed]
- Myronovskyi, M.; Tokovenko, B.; Manderscheid, N.; Petzke, L.; Luzhetskyy, A. Complete genome sequence of Streptomyces fulvissimus. J. Biotechnol. 2013, 168, 117–118. [Google Scholar] [CrossRef]
- Myo, E.M.; Ge, B.; Ma, J.; Cui, H.; Liu, B.; Shi, L.; Jiang, M.; Zhang, K. Indole-3-acetic acid production by Streptomyces fradiae NKZ-259 and its formulation to enhance plant growth. BMC Microbiol. 2019, 19, 155. [Google Scholar] [CrossRef]
- Mo, P.; Liu, J.; Zhao, Y.; Xu, Z. Streptomyces phaeolivaceus sp. nov. and Streptomyces broussonetiae sp. nov., isolated from the leaves and rhizosphere soil of Broussonetia papyrifera. Int. J. Syst. Evol. Microbiol. 2020, 70, 6458–6467. [Google Scholar] [CrossRef] [PubMed]
- Maciejewska, M.; Pessi, I.S.; Arguelles-Arias, A.; Noirfalise, P.; Luis, G.; Ongena, M.; Barton, H.; Carnol, M.; Rigali, S. Streptomyces lunaelactis sp. nov., a novel ferroverdin A-producing Streptomyces species isolated from a moonmilk speleothem. Antonie Van Leeuwenhoek 2015, 107, 519–531. [Google Scholar] [CrossRef] [PubMed]
- Ma, L.; Zhang, W.; Liu, Z.; Huang, Y.; Zhang, Q.; Tian, X.; Zhang, C.; Zhu, Y. Complete genome sequence of Streptomyces sp. SCSIO 03032 isolated from Indian Ocean sediment, producing diverse bioactive natural products. Mar. Genom. 2021, 55, 100803. [Google Scholar] [CrossRef]
- Lu, C.; Zhang, X.; Jiang, M.; Bai, L. Enhanced salinomycin production by adjusting the supply of polyketide extender units in Streptomyces albus. Metab. Eng. 2016, 35, 129–137. [Google Scholar] [CrossRef] [PubMed]
- Liu, W.; Sun, F.; Hu, Y. Genome Mining-Mediated Discovery of a New Avermipeptin Analogue in Streptomyces actuosus ATCC 25421. ChemistryOpen 2018, 7, 558–561. [Google Scholar] [CrossRef]
- Li, Y.; Zhang, C.; Liu, C.; Ju, J.; Ma, J. Genome sequencing of Streptomyces atratus SCSIOZH16 and activation production of nocardamine via metabolic engineering. Front. Microbiol. 2018, 9, 1269. [Google Scholar] [CrossRef] [PubMed]
- Li, Y.; Li, J.; Ye, Z.; Lu, L. Enhancement of angucycline production by combined UV mutagenesis and ribosome engineering and fermentation optimization in Streptomyces dengpaensis XZHG99T. Prep. Biochem. Biotechnol. 2021, 51, 173–182. [Google Scholar] [CrossRef]
- Li, K.; Tang, X.; Zhao, J.; Guo, Y.; Tang, Y.; Gao, J. Streptomyces cadmiisoli sp. Nov., a novel actinomycete isolated from cadmium-contaminated soil. Int. J. Syst. Evol. Microbiol. 2019, 69, 1024–1029. [Google Scholar] [CrossRef] [PubMed]
- Lee, J.Y.; Lee, J.Y.; Jung, H.W.; Hwang, B.K. Streptomyces koyangensis sp. nov., a novel actinomycete that produces 4-phenyl-3-butenoic acid. Int. J. Syst. Evol. Microbiol. 2005, 55, 257–262. [Google Scholar] [CrossRef] [PubMed][Green Version]
- Labana, P.; Gosse, J.T.; Boddy, C.N. Draft Genome Sequence of the Type Strain Streptomyces armeniacus ATCC 15676. Microbiol. Resour. Announc. 2018, 7. [Google Scholar] [CrossRef] [PubMed]
- Kim, M.K.; Kang, H.J.; Roh, S.G.; Park, J.S.; Kim, S.B. Streptomyces fodineus sp. nov., an actinobacterium with antifungal activity isolated from mine area soil. Int. J. Syst. Evol. Microbiol. 2019, 69, 1350–1354. [Google Scholar] [CrossRef]
- Jiang, L.; Pu, H.; Xiang, J.; Su, M.; Yan, X.; Yang, D.; Zhu, X.; Shen, B.; Duan, Y.; Huang, Y. Huanglongmycin A-C, cytotoxic polyketides biosynthesized by a putative type II polyketide synthase from Streptomyces sp. CB09001. Front. Chem. 2018, 6, 254. [Google Scholar] [CrossRef] [PubMed]
- Jankowitsch, F.; Schwarz, J.; Rückert, C.; Gust, B.; Szczepanowski, R.; Blom, J.; Pelzer, S.; Kalinowski, J.; Mack, M. Genome Sequence of the Bacterium Streptomyces davawensis JCM 4913 and Heterologous Production of the Unique Antibiotic Roseoflavin. J. Bacteriol. 2012, 194, 6818–6827. [Google Scholar] [CrossRef]
- Ishikawa, S.; Huang, M.; Tomita, A.; Kurihara, Y.; Watanabe, R.; Iwai, H.; Arakawa, K. Complete Genome Sequences of Four Bacteria Isolated from the Gut of a Spiny Ant (Polyrhachis lamellidens). Microbiol. Resour. Announc. 2022, 11, e0033322. [Google Scholar] [CrossRef] [PubMed]
- Hwang, S.; Lee, N.; Jeong, Y.; Lee, Y.; Kim, W.; Cho, S.; Palsson, B.O.; Cho, B.-K. Primary transcriptome and translatome analysis determines transcriptional and translational regulatory elements encoded in the Streptomyces clavuligerus genome. Nucleic Acids Res. 2019, 47, 6114–6129. [Google Scholar] [CrossRef]
- Huang, X.; Kong, F.; Zhou, S.; Huang, D.; Zheng, J.; Zhu, W. Streptomyces tirandamycinicus sp. Nov., a novel marine sponge-derived actinobacterium with antibacterial potential against Streptococcus agalactiae. Front. Microbiol. 2019, 10, 482. [Google Scholar] [CrossRef] [PubMed]
- Hu, S.; Wang, Y.; Wang, J.; Liu, K.; Tang, X.; Gao, J. Streptomyces xanthii sp. nov. and Streptomyces roseirectus sp. nov. isolated from a chinese medicinal plant. Int. J. Syst. Evol. Microbiol. 2021, 71, 004962. [Google Scholar] [CrossRef]
- Hrab, P.; Rückert, C.; Busche, T.; Ostash, I.; Kalinowski, J.; Fedorenko, V.; Yushchuk, O.; Ostash, B. Complete genome sequence of Streptomyces cyanogenus S136, producer of anticancer angucycline landomycin A. 3 Biotech 2021, 11, 282. [Google Scholar] [CrossRef] [PubMed]
- Holmes, N.A.; Devine, R.; Qin, Z.; Seipke, R.F.; Wilkinson, B.; Hutchings, M.I. Complete genome sequence of Streptomyces formicae KY5, the formicamycin producer. J. Biotechnol. 2018, 265, 116–118. [Google Scholar] [CrossRef]
- Han, X.; Li, M.; Ding, Z.; Zhao, J.; Ji, K.; Wen, M.; Lu, T. Genome Sequence of Streptomyces auratus Strain AGR0001, a Phoslactomycin-Producing Actinomycete. J. Bacteriol. 2012, 194, 5472–5473. [Google Scholar] [CrossRef] [PubMed][Green Version]
- Hamm, P.S.; Dunlap, C.A.; Mullowney, M.W.; Caimi, N.A.; Kelleher, N.L.; Thomson, R.J.; Porras-Alfaro, A.; Northup, D.E. Streptomyces buecherae sp. nov., an actinomycete isolated from multiple bat species. Antonie Van Leeuwenhoek Int. J. Gen. Mol. Microbiol. 2020, 113, 2213–2221. [Google Scholar] [CrossRef]
- Gu, Y.; Yang, C.; Wang, X.; Geng, W.; Sun, Y.; Feng, J.; Wang, Y.; Quan, Y.; Che, Y.; Zhang, C.; et al. Genome sequence of the ε-poly-L-lysine-producing strain Streptomyces albulus NK660, isolated from soil in Gutian, Fujian Province, China. Genome Announc. 2014, 2. [Google Scholar] [CrossRef] [PubMed]
- Gomez-Escribano, J.P.; Holmes, N.A.; Schlimpert, S.; Bibb, M.J.; Chandra, G.; Wilkinson, B.; Buttner, M.J.; Bibb, M.J. Streptomyces venezuelae NRRL B-65442: Genome sequence of a model strain used to study morphological differentiation in filamentous actinobacteria. J. Ind. Microbiol. Biotechnol. 2021, 48, kuab035. [Google Scholar] [CrossRef]
- Fu, J.; Zhong, C.; Zhao, Z.; Zong, G.; Cao, G. Complete genome sequence of a natural compounds producer, Streptomyces violaceus S21. Genom. Data 2017, 12, 116–117. [Google Scholar] [CrossRef]
- Feng, S.; Tang, S.; Jian, Y.; Huang, X.; Jin, L.; Zhu, Z.; Dong, P.; Li, Z. Complete Genome Sequence Data of a Novel Streptomyces sp. Strain A2-16, a Potential Biological Control Agent for Potato Late Blight. Plant Dis. 2022, 106, 723–726. [Google Scholar] [CrossRef] [PubMed]
- Erxleben, A.; Wunsch-Palasis, J.; Grüning, B.A.; Luzhetska, M.; Bechthold, A.; Günther, S. Genome sequence of Streptomyces sp. strain Tü6071. J. Bacteriol. 2011, 193, 4278–4279. [Google Scholar] [CrossRef]
- Duan, Z.; Liao, L.; Chen, B. Complete genome analysis reveals secondary metabolite biosynthetic capabilities of Streptomyces sp. R527F isolated from the Arctic Ocean. Mar. Genom. 2022, 63, 100949. [Google Scholar] [CrossRef] [PubMed]
- Doi, K.; Fujino, Y.; Nagayoshi, Y.; Ohshima, T.; Ogata, S. Complete genome sequence of thiostrepton-producing Streptomyces laurentii ATCC 31255D. Genome Announc. 2016, 4. [Google Scholar] [CrossRef]
- Dhakal, D.; Lim, S.K.; Kim, D.H.; Kim, B.G.; Yamaguchi, T.; Sohng, J.K. Complete genome sequence of Streptomyces peucetius ATCC 27952, the producer of anticancer anthracyclines and diverse secondary metabolites. J. Biotechnol. 2018, 267, 50–54. [Google Scholar] [CrossRef] [PubMed]
- Deng, M.R.; Guo, J.; Ma, L.Y.; Li, Y.X.; Feng, G.D.; Mo, C.Y.; Zhu, H.H. Complete genome sequence of Streptomyces vietnamensis GIMV4.0001 T, a genetically manipulable producer of the benzoisochromanequinone antibiotic granaticin. J. Biotechnol. 2015, 200, 6–7. [Google Scholar] [CrossRef]
- Chung, Y.-H.; Kim, H.; Ji, C.-H.; Je, H.-W.; Lee, D.; Shim, S.H.; Joo, H.-S.; Kang, H.-S. Comparative Genomics Reveals a Remarkable Biosynthetic Potential of the Streptomyces Phylogenetic Lineage Associated with Rugose-Ornamented Spores. mSystems 2021, 6. [Google Scholar] [CrossRef]
- Chen, J.; Hu, L.; Chen, N.; Jia, R.; Ma, Q.; Wang, Y. The Biocontrol and Plant Growth-Promoting Properties of Streptomyces alfalfae XN-04 Revealed by Functional and Genomic Analysis. Front. Microbiol. 2021, 12, 745766. [Google Scholar] [CrossRef]
- Chen, C.; Ye, Y.; Wang, R.; Zhang, Y.; Wu, C.; Debnath, S.C.; Ma, Z.; Wang, J.; Wu, M. Streptomyces nigra sp. nov. Is a novel actinobacterium isolated from mangrove soil and exerts a potent antitumor activity in vitro. Front. Microbiol. 2018, 9, 1587. [Google Scholar] [CrossRef] [PubMed]
- Busche, T.; Novakova, R.; Al’Dilaimi, A.; Homerova, D.; Feckova, L.; Rezuchova, B.; Mingyar, E.; Csolleiova, D.; Bekeova, C.; Winkler, A.; et al. Complete genome sequence of Streptomyces lavendulae subsp. lavendulae CCM 3239 (formerly “Streptomyces aureofaciens CCM 3239”), a producer of the angucycline-type antibiotic auricin. Genome Announc. 2018, 6. [Google Scholar] [CrossRef]
- Brautaset, T.; Sekurova, O.N.; Sletta, H.; Ellingsen, T.E.; Strøm, A.R.; Valla, S.; Zotchev, S.B. Biosynthesis of the polyene antifungal antibiotic nystatin in Streptomyces noursei ATCC 11455: Analysis of the gene cluster and deduction of the biosynthetic pathway. Chem. Biol. 2000, 7, 395–403. [Google Scholar] [CrossRef] [PubMed]
- Bown, L.; Bignell, D.R.D. Draft genome sequence of the plant pathogen Streptomyces sp. strain 11-1-2. Genome Announc. 2017, 5. [Google Scholar] [CrossRef]
- Bignell, D.R.D.; Selpke, R.F.; Huguet-Tapla, J.C.; Chambers, A.H.; Parry, R.J.; Lorla, R. Streptomyces scabies 87-22 contains a coronafacic acid-like biosynthetic cluster that contributes to plant-microbe interactions. Mol. Plant-Microbe Interact. 2010, 23, 161–175. [Google Scholar] [CrossRef]
- Bentley, S.D.; Chater, K.F.; Cerdeño-Tárraga, A.M.; Challis, G.L.; Thomson, N.R.; James, K.D.; Harris, D.E.; Quail, M.A.; Kieser, H.; Harper, D.; et al. Complete genome sequence of the model actinomycete Streptomyces coelicolor A3(2). Nature 2002, 417, 141–147. [Google Scholar] [CrossRef]
- Barry, C.P.; Gillane, R.; Talbo, G.H.; Plan, M.; Palfreyman, R.; Haber-Stuk, A.K.; Power, J.; Nielsen, L.K.; Marcellin, E. Multi-omic characterisation of Streptomyces hygroscopicus NRRL 30439: Detailed assessment of its secondary metabolic potential. Mol. Omics 2022, 18, 226–236. [Google Scholar] [CrossRef] [PubMed]
- Barreiro, C.; Prieto, C.; Sola-Landa, A.; Solera, E.; Martínez-Castro, M.; Pérez-Redondo, R.; García-Estrada, C.; Aparicio, J.F.; Fernández-Martínez, L.T.; Santos-Aberturas, J.; et al. Draft genome of Streptomyces tsukubaensis NRRL 18488, the producer of the clinically important immunosuppressant tacrolimus (FK506). J. Bacteriol. 2012, 194, 3756–3757. [Google Scholar] [CrossRef] [PubMed]
- Barbe, V.; Bouzon, M.; Mangenot, S.; Badet, B.; Poulain, J.; Segurens, B.; Vallenet, D.; Marlière, P.; Weissenbach, J. Complete Genome Sequence of Streptomyces cattleya NRRL 8057, a Producer of Antibiotics and Fluorometabolites. J. Bacteriol. 2011, 193, 5055–5056. [Google Scholar] [CrossRef]
- Badalamenti, J.P.; Erickson, J.D.; Salomon, C.E. Complete genome sequence of Streptomyces albus SM254, a potent antagonist of bat white-nose syndrome pathogen Pseudogymnoascus destructans. Genome Announc. 2016, 4. [Google Scholar] [CrossRef]
- Ai, L.; Geng, M.; Ma, M.; Bai, L. Complete Genome Sequence of the Ebosin-Producing Strain Streptomyces sp. 139. Microbiol. Resour. Announc. 2019, 8. [Google Scholar] [CrossRef]
- Nguyen, X.H.; Naing, K.W.; Lee, Y.S.; Tindwa, H.; Lee, G.H.; Jeong, B.K.; Ro, H.M.; Kim, S.J.; Jung, W.J.; Kim, K.Y. Biocontrol potential of Streptomyces griseus H7602 against root rot disease (Phytophthora capsici) in pepper. Plant Pathol. J. 2012, 28, 282–289. [Google Scholar] [CrossRef]
- Abbasi, S.; Safaie, N.; Sadeghi, A.; Shamsbakhsh, M. Tissue-specific synergistic bio-priming of pepper by two Streptomyces species against Phytophthora capsici. PLoS ONE 2020, 15, e0230531. [Google Scholar] [CrossRef]
- Trinidad-Cruz, J.R.; Rincón-Enríquez, G.; Evangelista-Martínez, Z.; Quiñones-Aguilar, E.E. Control biorracional de Phytophthora capsici en plantas de chile mediante Streptomyces spp. Rev. Chapingo Ser. Hortic. 2021, 27, 85–99. [Google Scholar] [CrossRef]
- Xu, M.J.; Wang, J.H.; Bu, X.L.; Yu, H.L.; Li, P.; Ou, H.Y.; He, Y.; Xu, F.D.; Hu, X.Y.; Zhu, X.M.; et al. Deciphering the streamlined genome of Streptomyces xiamenensis 318 as the producer of the anti-fibrotic drug candidate xiamenmycin. Sci. Rep. 2016, 6, 18977. [Google Scholar] [CrossRef]
- Caicedo-Montoya, C.; Manzo-Ruiz, M.; Ríos-Estepa, R. Pan-Genome of the Genus Streptomyces and Prioritization of Biosynthetic Gene Clusters With Potential to Produce Antibiotic Compounds. Front. Microbiol. 2021, 12, 677558. [Google Scholar] [CrossRef]
- Zaburannyi, N.; Rabyk, M.; Ostash, B.; Fedorenko, V.; Luzhetskyy, A. Insights into naturally minimised Streptomyces albus J1074 genome. BMC Genom. 2014, 15, 97. [Google Scholar] [CrossRef]
- Sharma, V.; Kaur, R.; Salwan, R. Streptomyces: Host for refactoring of diverse bioactive secondary metabolites. 3 Biotech 2021, 11, 340. [Google Scholar] [CrossRef]
- Weissman, J.L.; Fagan, W.F.; Johnson, P.L.F. Linking high GC content to the repair of double strand breaks in prokaryotic genomes. PLoS Genet. 2019, 15, e1008493. [Google Scholar] [CrossRef]
- Lacey, H.J.; Rutledge, P.J. Recently Discovered Secondary Metabolites from Streptomyces Species. Molecules 2022, 27, 887. [Google Scholar] [CrossRef] [PubMed]
- Jakubiec-Krzesniak, K.; Rajnisz-Mateusiak, A.; Guspiel, A.; Ziemska, J.; Solecka, J. Secondary metabolites of actinomycetes and their antibacterial, antifungal and antiviral properties. Pol. J. Microbiol. 2018, 67, 259–272. [Google Scholar] [CrossRef]
- Liu, Z.; Zhao, Y.; Huang, C.; Luo, Y. Recent Advances in Silent Gene Cluster Activation in Streptomyces. Front. Bioeng. Biotechnol. 2021, 9, 632230. [Google Scholar] [CrossRef] [PubMed]
- Ng, H.S.; Wan, P.K.; Kondo, A.; Chang, J.S.; Lan, J.C.W. Production and Recovery of Ectoine: A Review of Current State and Future Prospects. Processes 2023, 11, 339. [Google Scholar] [CrossRef]
- Sadeghi, A.; Soltani, B.M.; Nekouei, M.K.; Jouzani, G.S.; Mirzaei, H.H.; Sadeghizadeh, M. Diversity of the ectoines biosynthesis genes in the salt tolerant Streptomyces and evidence for inductive effect of ectoines on their accumulation. Microbiol. Res. 2014, 169, 699–708. [Google Scholar] [CrossRef] [PubMed]
- Pavan, M.E.; López, N.I.; Pettinari, M.J. Melanin biosynthesis in bacteria, regulation and production perspectives. Appl. Microbiol. Biotechnol. 2020, 104, 1357–1370. [Google Scholar] [CrossRef]
- McCormick, J.R.; Flärdh, K. Signals and regulators that govern Streptomyces development. FEMS Microbiol. Rev. 2012, 36, 206–231. [Google Scholar] [CrossRef]
- Jiang, J.; He, X.; Cane, D.E. Biosynthesis of the earthy odorant geosmin by a bifunctional Streptomyces coelicolor enzyme. Nat. Chem. Biol. 2007, 3, 711–715. [Google Scholar] [CrossRef] [PubMed]
- Becher, P.G.; Verschut, V.; Bibb, M.J.; Bush, M.J.; Molnár, B.P.; Barane, E.; Al-Bassam, M.M.; Chandra, G.; Song, L.; Challis, G.L.; et al. Developmentally regulated volatiles geosmin and 2-methylisoborneol attract a soil arthropod to Streptomyces bacteria promoting spore dispersal. Nat. Microbiol. 2020, 5, 821–829. [Google Scholar] [CrossRef] [PubMed]
- Churro, C.; Semedo-Aguiar, A.P.; Silva, A.D.; Pereira-Leal, J.B.; Leite, R.B. A novel cyanobacterial geosmin producer, revising GeoA distribution and dispersion patterns in Bacteria. Sci. Rep. 2020, 10, 8679. [Google Scholar] [CrossRef]
- Pérez-Corral, D.A.; Ornelas-Paz, J.d.J.; Olivas, G.I.; Acosta-Muñiz, C.H.; Salas-Marina, M.Á.; Berlanga-Reyes, D.I.; Sepulveda, D.R.; de León, Y.M.P.; Rios-Velasco, C. Growth Promotion of Phaseolus vulgaris and Arabidopsis thaliana Seedlings by Streptomycetes Volatile Compounds. Plants 2022, 11, 875. [Google Scholar] [CrossRef]
- Dotson, B.R.; Verschut, V.; Flärdh, K.; Becher, P.G.; Rasmusson, A.G. The Streptomyces volatile 3-octanone alters auxin/cytokinin and growth in Arabidopsis thaliana via the gene family KISS ME DEADLY. bioRxiv 2020. [Google Scholar] [CrossRef]
- Strock, C.F.; Lynch, J.P. Root secondary growth: An unexplored component of soil resource acquisition. Ann. Bot. 2020, 126, 205–218. [Google Scholar] [CrossRef] [PubMed]
- Sousa, J.A.d.J.; Olivares, F.L. Plant growth promotion by streptomycetes: Ecophysiology, mechanisms and applications. Chem. Biol. Technol. Agric. 2016, 3, 24. [Google Scholar] [CrossRef]
- Cocking, E.C. Helping plants get more nitrogen from the air. Eur. Rev. 2000, 8, 193–200. [Google Scholar] [CrossRef]
- Chouyia, F.E.; Ventorino, V.; Pepe, O. Diversity, mechanisms and beneficial features of phosphate-solubilizing Streptomyces in sustainable agriculture: A review. Front. Plant Sci. 2022, 13, 1035358. [Google Scholar] [CrossRef]
- Timofeeva, A.M.; Galyamova, M.R.; Sedykh, S.E. Bacterial Siderophores: Classification, Biosynthesis, Perspectives of Use in Agriculture. Plants 2022, 11, 3065. [Google Scholar] [CrossRef] [PubMed]
- Swarnalatha, G.V.; Goudar, V.; Gari Surendranatha Reddy, E.C.R.; Al Tawaha, A.R.M.; Sayyed, R.Z. Siderophores and Their Applications in Sustainable Management of Plant Diseases. In Secondary Metabolites and Volatiles of PGPR in Plant-Growth Promotion; Sayyed, R.Z., Uarrota, V.G., Eds.; Springer International Publishing: Cham, Switzerland, 2022; pp. 289–302. [Google Scholar]
- Chen, Y.Y.; Chen, P.C.; Tsay, T.T. The biocontrol efficacy and antibiotic activity of Streptomyces plicatus on the oomycete Phytophthora capsici. Biol. Control 2016, 98, 34–42. [Google Scholar] [CrossRef]
- Álvarez-Álvarez, R.; Botas, A.; Albillos, S.M.; Rumbero, A.; Martín, J.F.; Liras, P. Molecular genetics of naringenin biosynthesis, a typical plant secondary metabolite produced by Streptomyces clavuligerus. Microb. Cell Factories 2015, 14, 178. [Google Scholar] [CrossRef]
- Salehi, B.; Fokou, P.V.T.; Sharifi-Rad, M.; Zucca, P.; Pezzani, R.; Martins, N.; Sharifi-Rad, J. The therapeutic potential of naringenin: A review of clinical trials. Pharmaceuticals 2019, 12, 11. [Google Scholar] [CrossRef] [PubMed]
- Soberón, J.R.; Sgariglia, M.A.; Carabajal Torrez, J.A.; Aguilar, F.A.; Pero, E.J.I.; Sampietro, D.A.; Fernández de Luco, J.; Labadie, G.R. Antifungal activity and toxicity studies of flavanones isolated from Tessaria dodoneifolia aerial parts. Heliyon 2020, 6, e05174. [Google Scholar] [CrossRef]
- Zhang, L.; Zhang, H.; Huang, Y.; Peng, J.; Xie, J.; Wang, W. Isolation and Evaluation of Rhizosphere Actinomycetes With Potential Application for Biocontrolling Fusarium Wilt of Banana Caused by Fusarium oxysporum f. sp. cubense Tropical Race 4. Front. Microbiol. 2021, 12, 763038. [Google Scholar] [CrossRef]

| Strain Number | Medium | RNA 16S | Access Number | S. rolfsii | F. lateritium | M. phaseolina | C. coccodes | P.capici | F. oxysporum | F. salani |
|---|---|---|---|---|---|---|---|---|---|---|
| 1 | ISP2 | -− | − | + | ++ | − | ++ | − | ||
| 12 | AESM | − | − | − | − | − | − | − | ||
| 168 | SFM | − | ++ | ++ | ++ | − | − | − | ||
| 176 | Q1 | − | − | − | − | − | − | − | ||
| 196 | Starch | Streptomyces sp. | KY440748.1 | − | − | ++ | ++ | − | − | − |
| 209 | SFM | Streptomyces sp. | KY441440.1 | − | − | + | + | − | + | + |
| 217 | Starch | − | − | − | − | − | − | − | ||
| 222 | Q1 | − | − | ++ | − | − | − | − | ||
| 235 | Starch | Streptomyces sp. | KY441441.1 | − | − | + | − | − | − | − |
| 400 | Chitin | − | − | − | − | − | − | − | ||
| 407 | Starch | Streptomyces sp. | KY441443.1 | − | ++ | − | − | − | − | − |
| 410 | SFM | − | ++ | − | − | − | − | − | ||
| 510 | SFM | − | − | + | ++ | − | + | − | ||
| 511 | SFM | − | − | ++ | ++ | − | − | − | ||
| 516 | SFM | Streptomyces sp. | KY445386.1 | − | + | − | ++ | − | − | − |
| 518 | SFM | − | ++ | ++ | ++ | − | ++ | − | ||
| 561 | M2 | − | − | + | ++ | ++ | ++ | ++ | ||
| 562 | SFM | − | − | − | − | − | − | − | ||
| 563 | Q1 | − | − | + | ++ | − | + | − | ||
| 567 | Starch | − | − | ++ | ++ | − | + | − | ||
| 568 | M2 | − | − | − | − | − | − | − | ||
| 572 | SFM | − | − | − | − | − | − | − | ||
| 575 | SFM | − | − | − | − | − | − | − | ||
| 577 | SFM | Streptomyces sp. | KY445388.1 | − | − | − | − | − | − | − |
| 583 | SFM | − | ++ | − | − | − | − | − | ||
| 592 | SFM | − | − | ++ | ++ | + | − | + | ||
| 602 | SFM | − | − | − | − | − | − | − | ||
| 603 | ISP4 | − | + | + | ++ | + | − | − | ||
| 605 | SFM | Streptomyces sp. | KY445918.1 | − | − | − | − | − | − | − |
| 607 | Q1 | − | − | − | − | − | − | − | ||
| 608 | ISP3 | − | − | − | − | − | − | − | ||
| 612 | Q1 | Streptomyces sp. | KY445919 | − | − | − | − | − | − | − |
| 613 | Q1 | − | − | − | − | − | − | − | ||
| 616 | Q1 | − | − | − | − | − | − | − | ||
| 625 | Q1 | − | − | − | − | − | − | − | ||
| 636 | Q1 | Streptomyces sp. | KY508961 | − | − | − | − | − | − | − |
| 640 | Starch | − | − | − | − | − | − | − | ||
| 650 | Starch | − | − | − | − | − | − | − | ||
| 660 | SFM | − | − | − | − | − | − | − | ||
| 665 | Q1 | Streptomyces sp. | KY453992 | − | − | − | − | − | − | − |
| 666 | SFM | − | − | ++ | − | − | − | + | ||
| 667 | ISP4 | − | − | − | − | − | − | − | ||
| 668 | ISP4 | − | + | − | − | − | − | − | ||
| 669 | ISP4 | − | − | − | − | − | − | − | ||
| 670 | ISP4 | − | − | − | ++ | + | ++ | − | ||
| 672 | ISP3 | − | − | − | − | − | − | − | ||
| 673 | Q1 | Streptomyces sp. | KY453994.1 | − | − | ++ | ++ | − | − | − |
| 674 | ISP4 | − | − | − | − | − | − | − | ||
| 676 | ISP3 | Streptomyces sp. | KY453995 | − | − | − | − | − | − | + |
| 677 | HU | − | − | − | − | − | − | − | ||
| 678 | ISP3 | Streptomyces sp. | KY457841 | − | − | − | − | − | − | − |
| 698 | Q1 | Streptomyces sp. | KY454014 | − | + | − | ++ | − | + | − |
| PR12 | ISP2 | − | ++ | ++ | − | + | − | − | ||
| PR60 | − | − | − | − | − | − | − | |||
| PR69 | MBQ | − | ++ | ++ | ++ | ++ | + | + | ||
| PR79 | MBQ | − | − | − | − | − | − | − | ||
| PR105 | − | − | − | − | − | − | − | |||
| PR106 | − | − | − | − | + | ++ | − | |||
| PR107 | − | − | − | − | − | − | − | |||
| PR108 | − | − | + | − | − | − | − |
| Feature | |
|---|---|
| Contigs | 105 |
| Genome lenght | 6,570,163 bp |
| G+C % | 71.51 |
| Contig L50 | 12 |
| ContigN50 | 186,895 |
| CDS | 5956 |
| tRNA | 63 |
| rRNA | 4 |
| Protein with functional assignments | 3898 |
| Antibiotic resistance (sources: CARD, NDARO, and PATRIC) | 43 |
| Type | From–To (Location) | Most Similar Known Cluster | Similarity % | |
|---|---|---|---|---|
| Component | Type | |||
| Ectoine | 324,766–335,164 | Ectoine | Other | 100 |
| Melanin | 85,744–96,241 | Melanin | Other | 100 |
| Terpene | 223,129–244,059 | Geosmin | Terpene | 100 |
| T3PKS | 1–39,280 | Naringenin | Polyketide: Type III polyketide | 100 |
| Lanthipeptide Class III | 28,816–51,518 | SapB | RiPP: Lanthipeptide | 100 |
| Terpene | 1–16,602 | Pristinol | Terpene | 100 |
| NRPS-like, NRPS | 1–28,694 | Antipain | NRP | 83 |
| NRP—metallophore, NRPS, redox cofactor | 278,062–337,959 | Mirubactin | NRP | 78 |
| Terpene | 263,573–290,198 | Hopene | Terpene | 76 |
| Melanin | 101,546–111,953 | Grixazone A | Terpene | 61 |
| NRP—metallophore, NRPS, T1PKS | 160,886–250,379 | Peucechelin | NRP | 55 |
| T1PKS, T2PKS, RiPP-like | 160,514–249,283 | Xantholipin | Polyketide | 51 |
| NRPS | 1–37,748 | Netropsin | NRP | 40 |
| Phenazine | 20,316–40,780 | Endophenazine A/endophenazine B | Other: Phenazine | 33 |
| Melanin | 170,575–180,985 | Melanin | Other | 28 |
| T3PKS, NRPS | 79,735–109,902 | Totopotensamide A/totopotensamide B | NRP + Polyketide | 28 |
| NRPS, NRPS-like | 1–36,960 | Disgocidine/distamycin/congocidine | NRP | 28 |
| NRPS-like | 12,279–53,110 | Lipstatin | NRP | 21 |
| Terpene | 24,797–46,026 | Legonindolizidine A6 | NRP + Alkaloid | 12 |
| NI—siderophore | 132,640–147,396 | Synechobactin C9/C11/13/14/16/A/B/C | Other | 9 |
| NRPS-like | 43,673–85,050 | Chejuenolide A/chejuenolide B | Polyketide | 7 |
| RiPP-like | 151,678–160,095 | Hexacosalactone A | Other | 4 |
| NRPS-like | 109,671–132,257 | Sanglifehrin A | NRP + Polyketide | 4 |
| Thioamitides | 1–13,147 | Prejadomycin/rabelomycin/gauDimycin C/gaudimycin D/UWM6/gaudimycin A | Polyketide: Type II polyketide + saccharide: hybrid/tailoring saccharide | 4 |
| Other | 90,844–113,876 | A-503083 A/A-503083 B/A-503083 E/A-503083 F | NRP | 3 |
| Terpene | 54,693–71,392 | Bombyxamycin A/bombyxamycin B | Polyketide | 3 |
| CDPS | 66,910–87,659 | |||
| Indole | 1–19,239 | |||
| Characteristics | Streptomyces sp. PR69 |
|---|---|
| Cellulase | − |
| Protease | − |
| Chitinase | − |
| Lipase | + |
| Siderophores | + |
| Nitrogen fixation | + |
| Phosphate solubilization | − |
Disclaimer/Publisher’s Note: The statements, opinions and data contained in all publications are solely those of the individual author(s) and contributor(s) and not of MDPI and/or the editor(s). MDPI and/or the editor(s) disclaim responsibility for any injury to people or property resulting from any ideas, methods, instructions or products referred to in the content. |
© 2024 by the authors. Licensee MDPI, Basel, Switzerland. This article is an open access article distributed under the terms and conditions of the Creative Commons Attribution (CC BY) license (https://creativecommons.org/licenses/by/4.0/).
Share and Cite
López-Reyes, P.K.; De la Torre-Zavala, S.; Cortés-González, M.M.; Galán-Wong, L.J.; Avilés-Arnaut, H. Biological Control of Streptomyces sp. PR69 Against Phytophthora capsici and Its Growth-Promoting Effects on Plants. Horticulturae 2024, 10, 1365. https://doi.org/10.3390/horticulturae10121365
López-Reyes PK, De la Torre-Zavala S, Cortés-González MM, Galán-Wong LJ, Avilés-Arnaut H. Biological Control of Streptomyces sp. PR69 Against Phytophthora capsici and Its Growth-Promoting Effects on Plants. Horticulturae. 2024; 10(12):1365. https://doi.org/10.3390/horticulturae10121365
Chicago/Turabian StyleLópez-Reyes, Perla Karina, Susana De la Torre-Zavala, María Mercedes Cortés-González, Luis Jesús Galán-Wong, and Hamlet Avilés-Arnaut. 2024. "Biological Control of Streptomyces sp. PR69 Against Phytophthora capsici and Its Growth-Promoting Effects on Plants" Horticulturae 10, no. 12: 1365. https://doi.org/10.3390/horticulturae10121365
APA StyleLópez-Reyes, P. K., De la Torre-Zavala, S., Cortés-González, M. M., Galán-Wong, L. J., & Avilés-Arnaut, H. (2024). Biological Control of Streptomyces sp. PR69 Against Phytophthora capsici and Its Growth-Promoting Effects on Plants. Horticulturae, 10(12), 1365. https://doi.org/10.3390/horticulturae10121365

